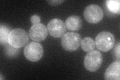
YDR046C
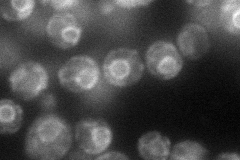
YDR046C
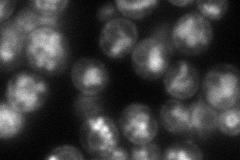
YDR046C
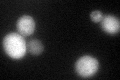
YDR046C

View description
Amino acid permease involved in the uptake of cysteine, leucine, isoleucine and valine
Localization:
Intensity:
Fold change:
Significance:
-
C’ GFP library in SD
vacuole membrane88.08 -
N' NOP1pr-GFP in SD
ER71.1106 -
N' TEF2pr-mCherry in SD
ER,vacuole69.8112 -
N' NATIVEpr-GFP in SD

ER18.5826 -
N' TEF2pr-VC and Cyto-VN in SD

ER,punctate37.1294 -
C’ GFP library in SD+DTT
vacuole membrane46.520.52Yes -
C’ GFP library in SD+H2O2

vacuoleN/AN/ANo -
C’ GFP library in Starvation Media

vacuoleN/AN/AYes -
C’ GFP library on the background of Pup2-DaMP

vacuole membrane -
C’ GFP library on the background of CCT mutant

vacuole membrane69.86720.793148No
